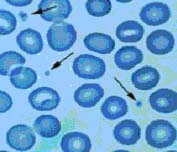

İmmün Trombositopenik Purpura
“Deri içine kanamalar sonucu oluşan küçük kırmızı döküntüler ve kolay çürük oluşumu kanamaya yatkınlığın sık rastlanan belirtilerindendir. Kanamaya yatkınlık yaratan kan hastalıklarından biri de ITP’dir.”
İmmün Trombositopenik Purpura (İTP)
İTP NEDİR?
İTP, immün trombositopenik purpura hastalığının kısaltmasıdır.
Bu hastalık
- İmmün bir hastalıktır. İmmün hastalıklar bağışıklık sisteminde oluşan bozukluklar nedeniyle vücudun kendi yapılarına saldırdığı hastalıklardır.
- Trombositopeni, yani trombosit (kan pulcukları) sayısının düşüklüğü ile seyreder.
- Trombosit sayısının düşüklüğü deri içine kanama nedeniyle oluşan peteşi ve ekimoz (çürük) dediğimiz kırmızı-mor renkte döküntülere sebep olur.
TROMBOSİT NEDİR? NE İŞE YARAR? NORMAL DEĞERLERİ NEDİR?
Şekil 1. Trombositler (kan pulcukları) kanın en küçük hücresel elemanlarıdır.

Şekil 2. Peteşi ve ekimoz (morluk)

Şekil 3a. Ağız içi kanama

Şekil 3b. Dudak iç kısmında kanama
Trombositler, kanamanın durdurulmasında rol oynarlar. Kanama bölgelerinde birbirlerine yapışarak bir tıkaç oluştururlar. Normalde kan sayımında 150.000-450.000/mm3 saptanır. 100.000 ile 150.000/mm3 arasında olduğunda genellikle klinik önemi düşük olmasına rağmen takip edilmesi gerekebilir.
İTP hastalığında trombosit sayısı 100.000/mm3’ün altına düşer. Trombosit sayısı azaldığında birbirlerine yapışmaları ve yeterli bir tıkaç oluşturmaları zorlaşır, buna bağlı olarak özellikle darbelerden sonra kanamalar uzun sürer.
Kanamalar aşağıdaki şekillerde olabilir:
1. Hastaların birçoğunda deri içine kanama sonucu kırmızı-mor renkte döküntüler olur.
2. Bazen ağız içinde kanama veya burun kanaması görülebilir.
3. Kadınlarda adet kanamaları uzayabilir veya kanama miktarı artabilir.
4. Daha nadiren idrardan kan gelmesi (idrar renginde pembeleşme veya çay rengi idrar), mide kanaması (kahve telvesi şeklinde kusma veya siyah renkli dışkılama), barsak kanaması (siyah veya vişne çürüğü renginde dışkılama) görülebilir.
5. Çok nadiren hayatı tehdit eden beyin kanaması olabilir.
Trombosit sayısı ne kadar düşükse, kanama riski o kadar fazla olmaktadır.
İTP’DE NEDEN TROMBOSİT SAYISI AZALIR? 
Bağışıklık sistemimiz yabancı organizmaları (bakteriler, virüsler, kanser hücreleri ve benzeri) tanır, antikor denen maddeler ile işaretler ve çöpçü hücreler tarafından işaretlenmiş hücreler yok edilir. İTP’de bilinmeyen bir nedenle bağışıklık sistemi trombositleri yabancı olarak işaretler ve bu da trombositlerin başta dalak olmak üzere savunmada görev alan organlarda parçalanmasına yol açar.
Çocuklarda görülen İTP ile erişkinlerde görülen İTP’nin seyri ve tedavisi farklıdır. Genellikle çocuklarda görülen İTP kısa sürelidir. Oysa erişkin hastalarda kronik (uzun süreli) olma eğilimindedir. Bazen İTP başka hastalıkların seyrinde (sistemik lupus eritematozus, bazı kanserler, bağışıklık bozuklukları, enfeksiyonlar) veya bazı ilaçlara bağlı olarak ortaya çıkabilir.
İTP HASTALIĞI NASIL TEŞHİS EDİLİR? 
Hastalığınızla ilgili öykü, fizik muayene bulguları, kan sayımı ve periferik kan yaymasının incelenmesi ile İTP ön tanısı konulabilir. Kesin tanı için trombositopeni yapan diğer hastalıkların olmadığının gösterilmesi gerekir. Bu amaçla hekiminizin gerekli gördüğü durumlarda bazı biyokimyasal testler, viral enfeksiyon taraması, kemik iliği incelemesi ve batın ultrasonografisi yapılmasına ihtiyaç duyulabilir.
İTP NASIL TEDAVİ EDİLİR? 
İTP’li hastalarda trombositopeni olmakla beraber, her zaman tedavi gerekmez. Tedavi kararı verirken kanama bulguları, periferik kan yayması ve trombosit sayısı beraber değerlendirilir. İTP hastası ağız içi kanama, burun kanaması, idrardan kan gelmesi, mide-barsak kanaması gibi ciddi kanama bulguları varlığı ve/veya kanama riski (olasılığı) değerlendirilerek veya trombosit sayısı 30.000/mm3 altında olduğunda tedavi edilebilir. Bazı hastalarda tek kürlük ilaç tedavisi ile kalıcı düzelme sağlanırken bazı hastalarda trombosit sayısı tekrar düşebilir ve ek tedavilere ihtiyacı olabilir. Tedavinin amacı hastalığı tamamıyla iyileştirmek değil, trombosit sayısını kanama için risk oluşturmayacak güvenli bir seviyeye yükseltmektir.
Uygulanan tedaviler genel olarak bağışıklık sisteminin geçici olarak baskılanmasını sağlayarak trombositlere karşı antikor gelişiminin engellenmesi ve dalakta trombositlerin parçalanmasının durdurulmasını sağlayarak etki eder. Bu amaçla kortikosteroid ilaçlar (kortizon), IVIG, anti-D ve hayatı tehdit eden kanamalarda trombosit süspansiyonu kullanılabilir. Bu ilaçlarla kalıcı bir etki elde edilemezse trombositlerin başlıca parçalandığı organ olan dalağın çıkartılması (splenektomi) gündeme gelebilir veya bağışıklık sistemini geçici baskılayan diğer ilaçlar ve kemik iliğinde trombosit üretimini artıran ilaçlar kullanılabilir. Hangi tedavi seçeneğinin uygulanacağına hastanın klinik durumu ve ek hastalıklarına göre karar verilir.
İTP İYİLEŞEN BİR HASTALIK MIDIR? 
Çocukluk çağında görülen İTP genelde ilk bir yıl içinde iyileşir. Ancak bazı çocuklar ve erişkin hastaların çoğunda iyileşemeyebilir. Bir yılı dolduran İTP, kronik İTP olarak adlandırılır, bu hastalarda tedavi seçenekleri tekrar gözden geçirilir.
İTP TEDAVİSİNDE KULLANILAN İLAÇLARIN YAN ETKİLERİ NELERDİR? 
1. Kortikosteroidler: İştahı arttırır ve vücutta su ve tuz tutulmasına neden olur. Kilo artışı, özellikle yüzde şişme, kızarma, gövdede yağ toplanması, kollarda ve bacaklarda incelme yapabilir. Bu nedenle kortikosteroid kullanırken, diyete dikkat edilmeli, fazla şekerli ve tuzlu yenmemelidir. Özellikle daha önceden şeker hastalığı (diyabet) olan kişilerin bu durumu doktoruna bildirmesi gerekmektedir. Bazen bilinen şeker hastalığı olmayan kişilerde de kan şekerinde aşırı yükselmeye neden olabilir. Eğer çok su içme, çok idrara çıkma ve halsizlik yakınmaları başlarsa mutlaka doktorunuza başvurunuz. Kortikosteroidler su ve tuz tutucu etkileri nedeniyle kan basıncını yükseltebilirler (hipertansiyon), tansiyonu yüksek olan kişilerde tansiyon ilacına rağmen dengesizlik olabilir. Kortikosteroid kullanırken mutlaka kan basıncınızı kontrol ettiriniz ve yüksekse doktorunuza bildiriniz. Kortikosteroidler ayrıca deride incelme, kızarma, karında mor çatlaklar, sivilceler, kadınlarda kıllanma ve adet düzensizlikleri yapabilir; seyrek olarak kemik başı aseptik nekrozu gelişebilir. Enfeksiyonlara, özellikle mantar enfeksiyonlarına eğilim artar. Bazı hastalarda psikolojik problemler (depresyon veya mani) görülebilir. Kortikosteroidlerin yan etkileri genellikle dozu ve kullanma süresi ile ilişkilidir. Uzun süreli kullanımlarda kemik erimesi, gözde katarakt, glokom gibi yan etkiler oluşabilir. Çocuklarda tüm bu yan etkilere ek olarak büyümede gerilik veya yavaşlama görülebilir. Bu nedenle özellikle kronik İTP hastalarında uzun süre yüksek doz kullanılmamaya çalışılır.
2. İntravenöz İmmünoglobulin (IVIG): IVIG insan plazmasından elde edilir. Virüs bulaşmasını engellemek için çeşitli işlemlerden geçirilir, bu nedenle güvenli olduğu kabul edilmektedir. Kırıklık, baş ağrısı, ateş, bulantı, titreme, çok nadiren ciddi ilaç reaksiyonları (anafilaksi) ve böbrek yetmezliğine neden olabilmektedir. Bu nedenle mutlaka hastanede doktor kontrolünde uygulanırlar. IVIG tedavisi alırken sıvı alımınızı artırmanız ve susuz kalmamanız önerilir.
3. Anti-D (Anti-Rh): Kan grubu Rh pozitif olan hastalarda kullanılabilir, ancak kansızlığa neden olabilir. Diğer yan etkileri IVIG’ye benzer.
4. Rituksimab: Bağışıklık sistemini geçici olarak baskılayabilir. Veriliş sırasında hafif cilt döküntüsü, ateş, nadiren hayatı tehdit eden allerjik reaksiyonlar (anafilaksi) sebep olabilir. Çok nadiren nörolojik yan etkileri olabilir. Hastanede doktor gözetimi altında verilir.
5. Eltrombopag/Romiplostim: Karaciğer enzimlerinde yükselme ve tromboza (damar tıkanıklığı) yol açabilir. Romiplostim isimli ilaç henüz Türkiye’de bulunmamaktadır, ancak yakın sürede kullanıma girmesi beklenmektedir.
SPLENEKTOMİ NEDİR? YAN ETKİLERİ VAR MIDIR? 
Dalağın ameliyatla çıkarılmasıdır. Splenektomi önemli bir cerrahi girişim olmakla beraber, günümüzde güvenli bir biçimde yapılabilmektedir. Gebelerde zorunlu olmadıkça uygulanmaz. Genellikle başlangıç tedavisine cevap vermeyen, kronik (hastalığı 12 aydan uzun süren) kişilerde uygulanır. Dalak kapsüllü mikroplara karşı vücudumuzu koruduğu için, dalağın çıkarılması bazı mikroplara karşı savunmasız kalmamıza neden olabilir. Bu nedenle splenektomi ameliyatından önce mutlaka pnömokok, hemofilus influenza tip B ve meningokok aşıları yapılır. Bu aşıların her 5 yılda bir tekrarlanması önerilir.
İTP HASTALIĞI BULAŞICI MIDIR? 
Hayır, kesinlikle bulaşıcı değildir. Gebelikte İTP hastalığı olanlarda, bebeğe bir miktar antikor geçebilir, ancak yapılan çalışmalarda çocukta genellikle bir problem oluşmadığı gösterilmiştir. Geçici bir trombosit düşüklüğü olan bebekler kısa zamanda düzelmektedir. Doğumdan önce takip eden doktorunuza İTP hastası olduğunuzu bildirmeyi unutmayınız.
İTP’LİLERDE BAŞKA HASTALIKLARA YAKALANMA SIKLIĞI ARTAR MI? 
İTP hastalığı başka hastalıklara yakalanmanızı kolaylaştırmaz. Ancak hastalığın tedavisinde kullanılan ilaçlar vücudun direncini etkileyebilir. Kullandığınız ilaçların yan etkileri konusunda doktorunuzdan bilgi isteyiniz. Seyrek olarak İTP tanısı almış hastalarda zamanla başka romatizmal hastalıklar ortaya çıkabilir.
İTP HASTALIĞI KİŞİNİN ÖMRÜNÜ KISALTIR MI? 
İTP hastalığının kendisi hayatınızı kısaltmaz. Ancak kontrolsüz diyabet, hipertansiyon, ülser, kalp hastalığı gibi durumların bulunması ve splenektomi ameliyatı sırasında oluşabilecek sorunlar hayatı tehdit eden durumların ortaya çıkmasına neden olabilir. Splenektomi öncesi aşıları tam yapılan, gerekli korunma işlemleri tamamlanan ve diğer hastalıkları kontrol altında olan kişilerde genellikle güvenli bir şekilde splenektomi gerçekleştirilir.
İTP’Lİ HASTALARIN DİKKAT ETMESİ GEREKEN DURUMLAR NELERDİR? 
Eğer trombosit sayınız normalden düşük ise aşağıdaki durumlarda dikkat etmelisiniz:
1. Ağrı kesici ilaç kullanımı: Herhangi bir nedenle ağrı kesici kullanmanız gerektiğinde doktorunuza başvurunuz. Aspirin ve pek çok ağrı kesici ilaç trombositlerin fonksiyonlarını bozar ve tehlikeli kanamalara neden olabilir. Özellikle aspirin içeren ilaçların alınması çok zararlıdır. Asetaminofen veya parasetamol grubu ilaçlar (Minoset, Parol, Tylol ve benzeri) kullanılabilir.
2. Diş tedavisi: Dişlerin yumuşak diş fırçası ile mümkün olduğunca düzenli olarak fırçalanması ve ağız hijyenine dikkat edilmesi önerilir. Dolgu, diş çekimi, diş taşı temizliği gibi işlemlerde aşırı kanama olabilir, mutlaka doktorunuza danışınız.
3. Enfeksiyonlardan korunma: Bulaşıcı hastalığı olan kişiler ile yakın temastan kaçınınız. Viral enfeksiyonlar trombosit değerlerinizde düşmeye yol açabilir.
4. Cerrahi girişim: Herhangi bir cerrahi girişim yapılması gerekirse doktorunuza İTP hastası olduğunuzu mutlaka belirtiniz.
5. Kadınlarda adet kanamaları: Trombosit sayısının düşüklüğüne göre her zamankinden çok ve uzun süren kanamanız olursa doktorunuzu bilgilendiriniz.
6. Gebelik: Gebelikte trombosit sayısı normal kişilerde de azalabilir, ancak genellikle hafif trombositopeni şeklindedir. İTP hastalığı olanlarda ağır trombositopeni gelişebilir. Bu nedenle mutlaka düzenli aralıklarla kan sayımı yapılmalıdır. Eğer trombosit değeri çok düşerse, kortikosteroidler ve azatioprin her trimesterde kullanılabilir. Kortikosteroidler etkili olmazsa doğum sırasında IVIG veya trombosit süspansiyonu ile destek yapılır. Doğum öncesi de İTP hastalığınızı mutlaka doktorunuza hatırlatınız.
7. Travmadan korunma: Temas sporları gibi kanama riski olan aktivitelerden uzak durulmalıdır. Ayrıca İTP’li çocuğunuzu yaptığı fiziksel aktivitenin şiddetine göre kasket/dizlik/dirseklik gibi koruyucu malzemeler giydirerek koruyabilirsiniz. Çocuğunuzu düşme veya kafa travması riski olan fiziksel aktivitelerden uzak tutunuz. Çocuğunuzu çok sıcak havalarda mümkün olduğunca serin yerde tutunuz ve dışarıya çıkarken gölgelikli bir şapka takınız.
8. Aşılar: Doktorunuza danışarak uygulama yapılmalıdır.
|